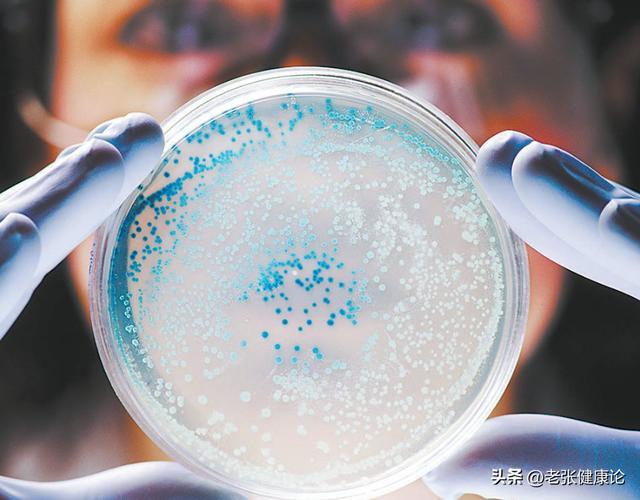

“你听说没有?现在外面卖的鸡蛋专业在线股票配资交易平台,很多都是打了激素的,吃多了会得癌。”小区里一大早,门口大妈们又开始新一轮“健康讨论”。60岁的老刘一听,立马把家里刚买的两板鸡蛋塞给了儿子:“你们年轻,扛得住,我们不敢吃了。”
结果儿媳妇急得直笑:“爸,现在还有‘激素鸡蛋’这说法?你先别急着送人,咱搞清楚再说。”到底有没有所谓“大量激素鸡蛋流入市场”?鸡蛋真会“有毒致癌”吗?是不是干脆少吃,或者只吃“土鸡蛋”才安全?

别被一句“激素”“致癌”吓得什么都不敢吃。鸡蛋到底安不安全,关键不在“是不是激素鸡蛋”,而在你吃的“哪几种蛋”、怎么吃、吃多少。接下来就把这个热门谣言掰开揉碎,尤其是最后一种“要少吃的蛋”,很多人天天在吃却以为很健康。
先说结论:正规养殖鸡蛋里,国家明令禁止添加生长激素,也没有所谓“打了激素长大的鸡蛋”。
现代养殖鸡长得快,主要原因是:选育品种,像人种庄稼一样,选生长快的品种;;合理饲料,蛋白、能量配比更科学;养殖环境,恒温、控光,让鸡更“高效下蛋”。
国家对家禽饲料中激素类药物有严格禁用目录,正规养殖场一旦被查出使用,几乎等于“砸锅”。
鸡蛋里本身会含有微量天然激素,这是所有动物性食物都存在的,不是人为添加,正常吃完全在人体可代谢范围内,与“致癌”相差十万八千里。

真正让鸡蛋“伤身”的,往往不是激素,而是以下这几类“问题吃法”和“问题鸡蛋”。
长期这样吃,鸡蛋可能真会“拖累健康”
坚持吃鸡蛋,多数对健康有利,但这三种蛋,要少吃或别吃:
“煎到焦边的鸡蛋”,油脂+高温=心血管负担:很多人爱吃两面煎到金黄甚至微焦的鸡蛋,看着香,其实对血管不友好。高温煎炸会产生氧化胆固醇,有研究发现,其更容易参与动脉粥样硬化过程。
一次煎蛋往往要放10~15克油,热量瞬间上去,长期超标易导致体重上升、血脂异常。对于本身就有冠心病、脑梗、脂肪肝风险的人,更不建议天天煎着吃。建议:平时多用水煮、蒸、荷包少油的方式,既保留营养,又避免多余油脂。
“反复加热的隔夜蛋”,细菌、营养双重打折:早上煮一大锅鸡蛋,放到第二天、第三天慢慢吃,很多家庭都这样图省事。
问题在于:鸡蛋剥壳后,若在室温下放置超过2小时,细菌繁殖明显增加;反复加热会让蛋白质进一步变性凝固,口感变老,消化吸收反而变差;若和凉菜、拌菜一起放,细菌污染风险更高。
建议:鸡蛋最好是现煮现吃,剥壳后若吃不完,尽量在24小时内冷藏保存,再次食用时要加热透,不要多次热了又凉。
“腌得过咸的咸蛋、皮蛋”,钠超标,伤血压又伤肾:咸蛋、咸鸭蛋、皮蛋,不少中老年人爱当小菜,但真正要提醒“少吃”的,反而是这类蛋。传统腌制咸蛋,钠含量非常高,经常吃容易导致血压上升、水肿。
有研究提示,高盐饮食与胃癌、心血管事件风险增加相关。某些劣质皮蛋可能含有重金属污染(正规合格产品风险已大大降低,但散装来源不明的要警惕)。

建议:有高血压、肾病、心衰的人,咸蛋类尽量当“偶尔解馋”,而不是每天的固定搭配;选择正规品牌包装的皮蛋、咸蛋,减少重金属和微生物污染风险;一周吃咸蛋类控制在1~2个以内更稳妥。
怎么吃鸡蛋,更安全也更健康?
如果没有对鸡蛋过敏,大多数成年人每天吃1~2个鸡蛋是相对合适的量。想吃得安心,可以这样做。
优先选择正规超市、品牌鸡蛋,不迷信“土鸡蛋就一定更安全”;烹调方式以水煮、蒸、少油煎为主,避免长期吃重油、重盐、焦糊蛋;搭配全谷物、蔬菜一起吃,比如鸡蛋配杂粮粥、全麦面包,而不是总配油条、培根;本身有高血脂、冠心病的人,更要关注整体饮食结构,而不是单盯着鸡蛋本身。鸡蛋不是“激素炸弹”,也不是“绝对完美食物”,关键还是:选对来源、吃对方式、控制好量。

参考资料:
中华预防医学会.《中国居民膳食指南(2022)》
中华医学会心血管病学分会.《高血压患者生活方式管理专家共识》
中华医学会肾脏病学分会.《慢性肾脏病营养管理共识》
中国营养学会.《中国居民膳食营养素参考摄入量(DRIs)》专业在线股票配资交易平台
展博优配提示:文章来自网络,不代表本站观点。